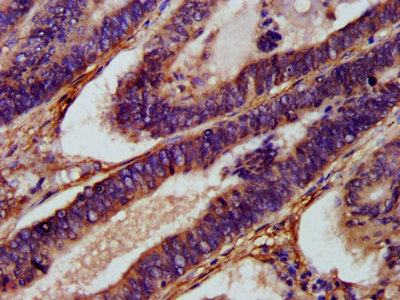
IHC image of CSB-PA875681LA01HU diluted at 1:1000 and staining in paraffin-embedded human colon cancer performed on a Leica BondTM system. After dewaxing and hydration, antigen retrieval was mediated by high pressure in a citrate buffer (pH 6.0). Section was blocked with 10% normal goat serum 30min at RT. Then primary antibody (1% BSA) was incubated at 4°C overnight. The primary is detected by a biotinylated secondary antibody and visualized using an HRP conjugated SP system. IHC image of CSB-PA875681LA01HU diluted at 1:1000 and staining in paraffin-embedded human colon cancer performed on a Leica BondTM system. After dewaxing and hydration, antigen retrieval was mediated by high pressure in a citrate buffer (pH 6.0). Section was blocked with 10% normal goat serum 30min at RT. Then primary antibody (1% BSA) was incubated at 4°C overnight. The primary is detected by a biotinylated secondary antibody and visualized using an HRP conjugated SP system.

Western Blot Positive WB detected in: K562 whole cell lysate, 293T whole cell lysate All lanes: XKR8 antibody at 3.4microg/ml Secondary Goat polyclonal to rabbit IgG at 1/50000 dilution Predicted band size: 45 kDa Observed band size: 45 kDa
XKR8 Antibody
CSB-PA875681LA01HU
ApplicationsImmunoFluorescence, Western Blot, ELISA, ImmunoHistoChemistry
Product group Antibodies
ReactivityHuman
TargetXKR8
Overview
- SupplierCusabio
- Product NameXKR8 Antibody
- Delivery Days Customer20
- ApplicationsImmunoFluorescence, Western Blot, ELISA, ImmunoHistoChemistry
- CertificationResearch Use Only
- ClonalityPolyclonal
- ConjugateUnconjugated
- Gene ID55113
- Target nameXKR8
- Target descriptionXK related 8
- Target synonymsXRG8, hXkr8, XK-related protein 8, X Kell blood group precursor-related family, member 8, X-linked Kx blood group related 8, XK, Kell blood group complex subunit-related family, member 8
- HostRabbit
- IsotypeIgG
- Protein IDQ9H6D3
- Protein NameXK-related protein 8
- Scientific DescriptionPromotes phosphatidylserine exposure on apoptotic cell surface, possibly by mediating phospholipid scrambling. Phosphatidylserine is a specific marker only present at the surface of apoptotic cells and acts as a specific signal for engulfment. Has no effect on calcium-induced exposure of phosphatidylserine. Activated upon caspase cleavage, suggesting that it does not act prior the onset of apoptosis.
- ReactivityHuman
- Storage Instruction-20°C or -80°C
- UNSPSC41116161